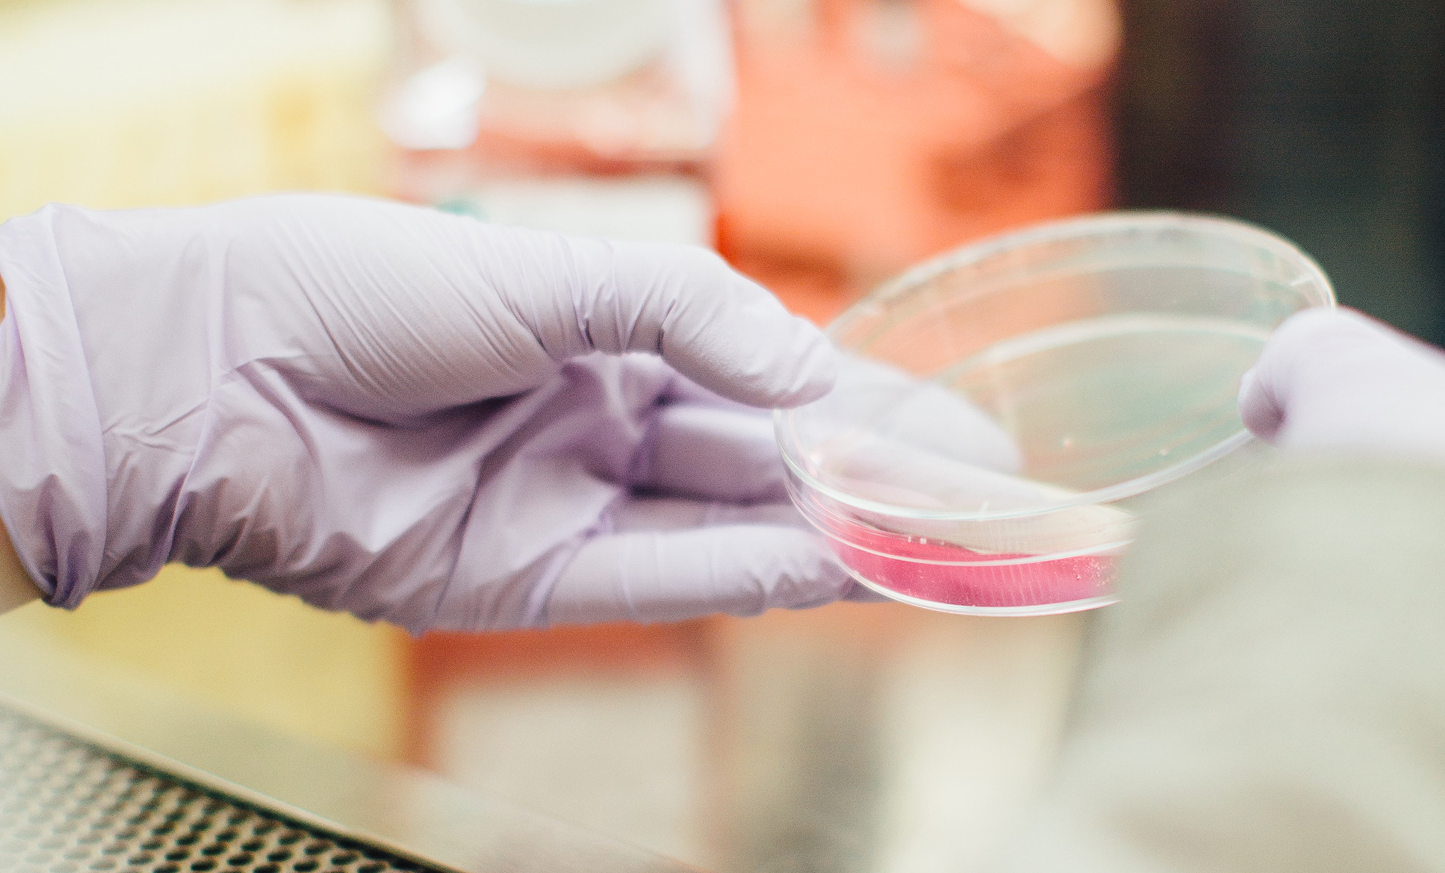

Why a Research Plan?
Before redesigning the CASA Lite dashboard, a structured UX research plan was needed to ensure decisions were grounded in real user needs, not assumptions.
This plan defined the scope, methods, and timeline to evaluate the current interface and identify opportunities for improvement across the Quality Control workflow.
Research objectives
Primary objective: Identify usability issues and pain points in the existing CASA Lite interface used by lab technicians and clinical staff.
Secondary objectives:
- Understand the daily workflow of QC operators
- Evaluate learnability for new users
- Assess data visualisation clarity
- Collect evidence to prioritise redesign decisions

UX Research Plan — CASA Lite Quality Control dashboard